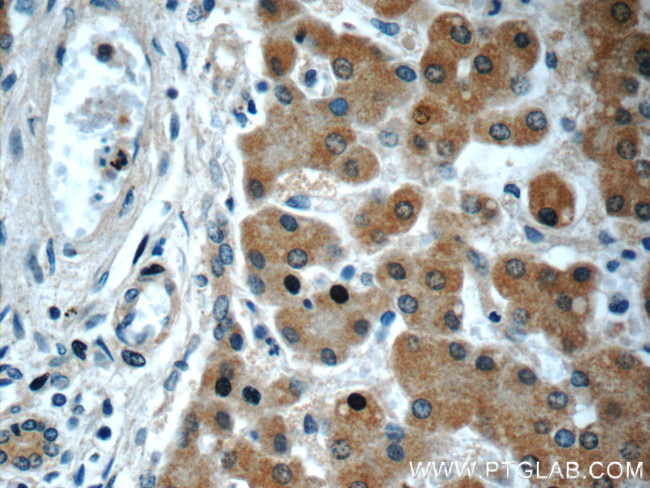
GOSR2/Membrin Antibody in Immunohistochemistry (Paraffin) (IHC (P))
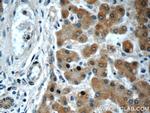
GOSR2/Membrin Antibody in Immunohistochemistry (Paraffin) (IHC (P))

Search
Proteintech
GOSR2/Membrin Monoclonal Antibody (7E7C7)
{{$productOrderCtrl.translations['antibody.pdp.commerceCard.promotion.promotions']}}
{{$productOrderCtrl.translations['antibody.pdp.commerceCard.promotion.viewpromo']}}
{{$productOrderCtrl.translations['antibody.pdp.commerceCard.promotion.promocode']}}: {{promo.promoCode}} {{promo.promoTitle}} {{promo.promoDescription}}. {{$productOrderCtrl.translations['antibody.pdp.commerceCard.promotion.learnmore']}}
产品信息
66134-1-IG
种属反应
宿主/亚型
分类
类型
克隆号
抗原
偶联物
形式
浓度
规格
纯化类型
保存液
内含物
保存条件
运输条件
产品详细信息
Immunogen sequence: MDPLFQQTH KQVHEIQSCM GRLETADKQS VHIVENEIQA SIDQIFSRLE RLEILSSKEP PNKRQNARLR VDQLKYDVQH LQTALRNFQH RRHAREQQER QREELLSRTF TTNDSDTTIP MDESLQFNSS LQKVHNGMDD LILDGHNILD GLRTQRLTLK GTQKKILDIA NMLGLSNTVM RLIEKRAFQD KYF (1-192 aa encoded by BC009710)
靶标信息
This gene encodes a trafficking membrane protein which transports proteins among the medial- and trans-Golgi compartments. Due to its chromosomal location and trafficking function, this gene may be involved in familial essential hypertension. Three transcript variants encoding three different isoforms have been found for this gene.
仅用于科研。不用于诊断过程。未经明确授权不得转售。
生物信息学
蛋白别名: 27 kDa Golgi SNARE protein; alternatively spliced; Golgi SNAP receptor complex member 2; Membrin; RP23-272P17.5; unnamed protein product
基因别名: Bos1; EPM6; GOSR2; GS27; MYOS
UniProt ID: (Human) O14653, (Rat) O35165
Entrez Gene ID: (Human) 9570, (Rat) 64154